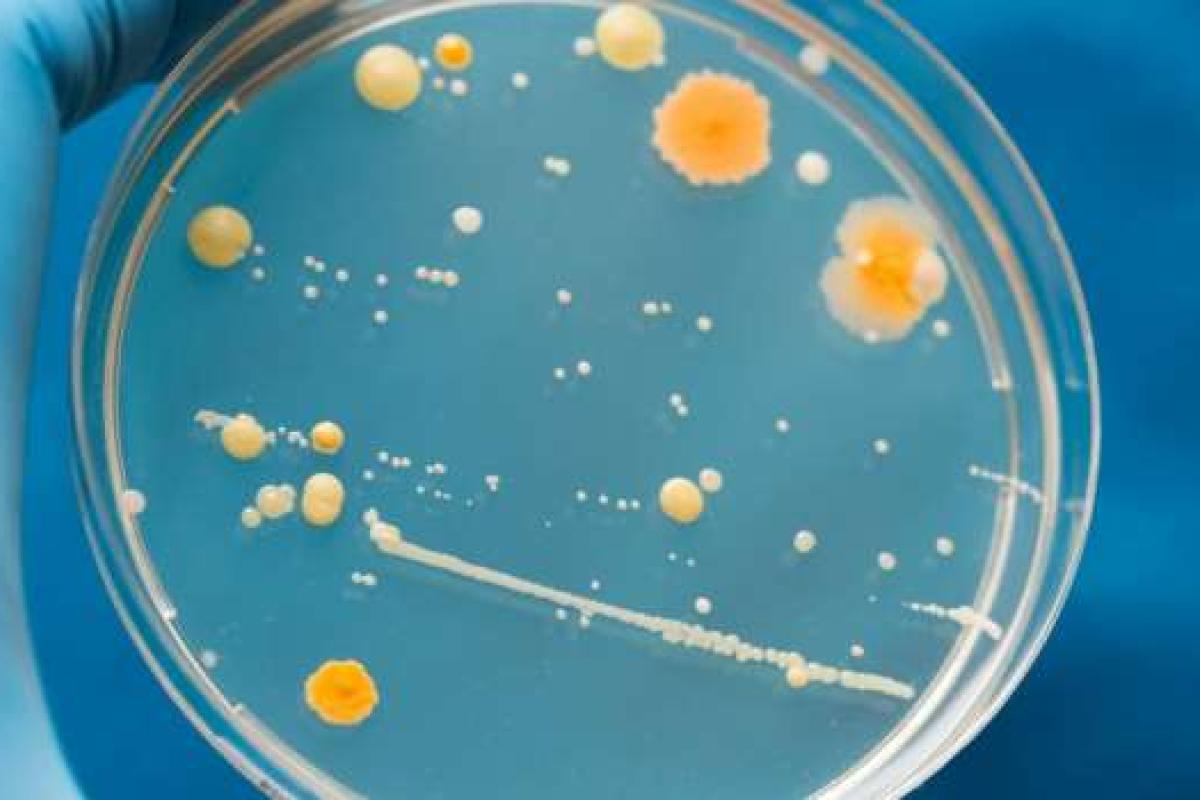
Опасно для жизни: названа самая грязная вещь, которой люди касаются каждый день Опасно для жизни: названа самая грязная вещь, которой люди касаются каждый день

На протяжении всей своей истории человечество сосуществует с различными микроорганизмами. Некоторые из них полезны - помогают переваривать пищу или защищают от болезнетворных инфекций, другие же могут вызывать опасные заболевания.
Благодаря иммунной системе человек может сталкиваться с болезнетворными микробами каждый день и при этом не заболевать. Если бы не иммунитет - страшные эпидемии были бы неизбежными, ведь с рассадниками опасных инфекций люди контактируют ежедневно, передает Час Пик со ссылкой на СМИ.
Ученые выяснили, что самый грязный предмет, которым пользуется человек - это отнюдь не унитаз, а мобильный телефон. На экране смартфона скапливается кожный жир и другие биологические среды, в которых прекрасно себя чувствуют возбудители разных болезней. К этому следует добавить и тот факт, что при работе телефон нагревается, из-за чего размножение бактерий становится еще интенсивнее.
По информации экспертов, на экране смартфона могут жить в том числе микробы, вызывающие смертельно опасные заболевания. С малым количеством бактерий наша иммунная система еще может справиться, но если они будут слишком активно размножаться - последствия могут быть печальными.
Чтобы избежать заражения, медики рекомендуют протирать экран смартфона спитром или перекисью водорода. Также нужно стараться поменьше касаться гаджета грязными, потными руками.
В рейтинге самых грязных предметов также оказались поручни в общественном транспорте, ручки корзин и тележек в магазинах и клавиатура компьютера. Что интересно, унитаз, который чаще всего ассоциируется с грязью и микробами, в "лидерах" этого рейтинга не значится. Всё потому, что бактериям довольно сложно "зацепиться" за керамику, из которой сделана сантехника.
















